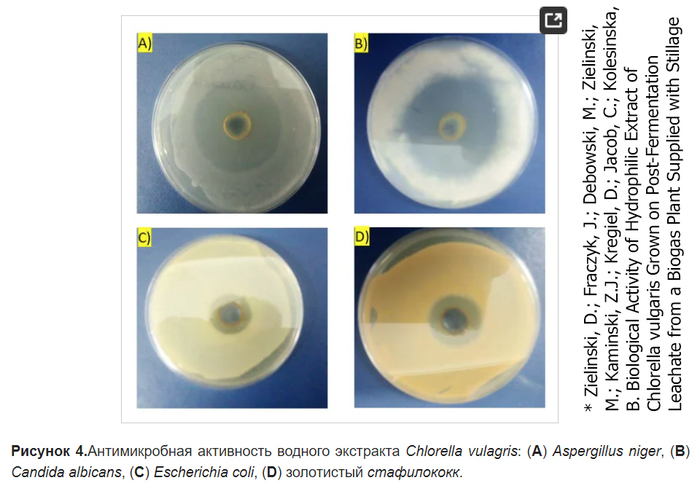

BOB MARLEY & The Wailers - это ЗАВОРАЖИВАЮЩЕЕ ВОЛШЕБСТВО сплава регги и рока!
BOB MARLEY & The Wailers... Просто ПОСЛУШАЙТЕ как поет чувак, ПОСМОТРИТЕ как держится на сцене, и как играет и иногда катается по сцене его гитарист. Невероятная аура исходит от музыкантов!
Ответ nk4vr в «Ответ на пост "С чем вы сталкивались, что в реальности случается раз на миллион?"»61
История по сравнению с другими не супер супер. Но все же. В 22 году полетели в Сочи, жили в Адлере. Но только 3 дня. Остальной отпуск жили в других частях Сочи.
И вот жена с ребенком лежат на пляже, а я пошел искать нам ресторан. Наткнулся на соседей из моего подъезда. Тоже приехали в Адлер. Причем в доме много квартир, но встретил я именно тех соседей с которыми ближе всего общаюсь. Мы не разминулись ни днём ни минутой.
Потом еще через день их встретил опять на набережной примерно в том же месте 🤣🤷♂️ Ну вот они шли и я шел. Иди я минутой позже и все. Как???
Придетели домой. Почти в первый же день иду в магазин и встречаю девушку (жену) из этой семьи на кассе магазина 🤣🤷♂️
Это было странно 🤔😃
"На побывку едет молодой моряк, грудь его в медалях, ленты в якорях!"
В завершение этого праздничного дня хочу поделиться замечательной песней "На побывку едет" композитора Александра Аверкина на слова Виктора Бокова. Поют Юрий Алексеев и Валентина Готовцева в сопровождении Образцового оркестра Военно-Морского Флота п/у Владимира Солодахина.
1987 г. Источник: канал на YouTube «Советское телевидение. Гостелерадиофонд России», www.youtube.com/c/gtrftv
Битва с плесенью
Всем привет! Столкнувшись с проблемой плесени в прошлый раз, я решил погрузиться в этот вопрос по-глубже и узнать, какой из доступных способов борьбы с ней наиболее эффективный.
Для этого я взял 6 баночек по 100 мл и поместил в них по 3 одинаковые семечки. В каждую банку, кроме первой, налил разные растворы, которые могут подавлять развитие патогенной флоры.
Получилась следующая маркировка: 0 – контроль, 1 – перекись водорода 3 мл, 2 – слабый раствор марганцовки, 3 – хлоргексидин, 4 – биопрепарат триходерма вериде, 5 – суспензия хлореллы.
Что касается хлореллы, обычно она используется для стимуляции прорастания семян, а не для их дезинфекции. Однако доказано, что эта микроводоросль выделяет антибиотик широкого спектра и я решил проверить, действует ли он на плесневые грибы.
Замачивать семена буду 12 часов, после чего пересажу их на питательную среду, на которой и буду наблюдать наличие или отсутствие плесени. Для приготовления среды необходимо 200 мл воды довести до кипения, после чего добавить 6г агара и варить на медленном огне 10 минут, постоянно помешивая. За неимением чашек Петри буду использовать баночки всем известного бренда. Разливаем полученный раствор, плотно закручиваем крышки и ставим на 20 минут в пароварку для дезинфекции.
После остывания банок с агаром аккуратно, стараясь не открывать широко крышку, переносим семена на среду, плотно закрываем и убираем в теплое место.
Спустя 3 дня настало время подвести итоги. Сказать сразу, результатами я не вполне доволен. Вопреки расхожим мнениям, перекись водорода справилась со своей задачей лучше других. Помимо фунгицидного действия, она также простимулировала всхожесть, в результате чего все 3 семячки проросли на агаре.
Чуть хуже, но также хорошо справилась марганцовка:
Остальные образцы показали неудовлетворительный результат. Особенно разочарован я в триходерме, но полагаю, что в руки мне попался некачественный биопрепарат.
Друзья, спасибо, что дочитали до конца. Думаю, что такие маленькие опыты будут не лишними на моем канале. Хочу провести еще несколько с другими веществами и биопрепаратами. Оставайтесь на канале, чтобы ничего не пропустить, а также делитесь своими идеями и мыслями на этот счет. До скорого!
Начитался...
Всем привет!
на данном ресурсе обычно читаю все, что попадется, хотя жена частенько целенаправленно заходит в разные сообщества и черпает инфу и истории оттуда. Вот и я наткнулся на подписанное сообщество Алкобушников и решил также позалипать.
В глаза бросился пост с обзором пива с очень красивой этикеткой. Прочитал, потом еще один, потом еще, потом перешел через рекомендации в посте на еще одного обзорщика (надеюсь не обижу их таким словом), читал пару часов, было действительно интересно.
Я не пивной сомелье и не разбираюсь в сортах хмеля, знаю лагер и стаут, и все в таком роде, но нотки каштана или спелого сельдерея - это не про меня.
По случаю мужского праздника разместил заказ жене на несколько банок на ее усмотрение (люблю гозе).
Коротко и просто слева направо:
1. Drunk Tomato. Пивной томатный сок. Приятный, хочется пить по чуть-чуть при разговоре, несильно насыщенный.
2. Tomato Method EXTRA HOT. Ужас, еле допил. Острота на 19 из 10.
3. Выделяется Стаут с ягодами. Норм, но больше не куплю. Густой и насыщенный, такой не для меня.
4. Украинский борщ. ТОП! КУПЛЮ ЕЩЕ! Необычно на 16 из 10, НО, мне зашло!
На этом все. Не обзор, но начитался @damanosobachka, @MeIIIoKXyEB, (если правильно запомнил) и решил тоже поделиться.